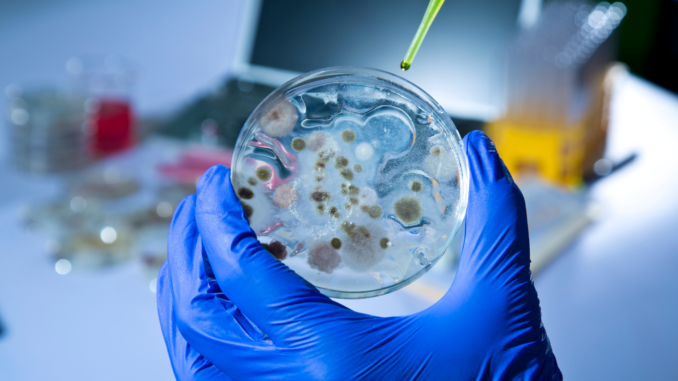
Keime

Die Resistenz vieler Keime gegen Antibiotika ist einer Studie zufolge deutlich verbreiteter als bisher angenommen: Rund 1,2 Millionen Menschen sind demnach im Jahr 2019 an einer Infektion mit multiresistenten Erregern gestorben, bei bis zu 3,68 Millionen Todesfällen spielte die Antibiotikaresistenz zumindest eine Rolle, wie die am Donnerstag in der Fachzeitschrift „Lancet“ veröffentlichte Untersuchung ergab. Ko-Autor Chris Murray sieht dringenden Handlungsbedarf.
Nach Angaben der Forscher handelt es sich bei ihrer Studie um die bisher umfassendste Analyse der Auswirkungen der Antibiotikaresistenz. Sie basiert unter anderem auf Daten aus öffentlichen Gesundheitssystemen, pharmazeutischen Überwachungsnetzen und früheren Studien. Für Teile der Welt, insbesondere für Länder mit niedrigem und mittlerem Einkommen, lagen allerdings keine Daten vor. Hier mussten sich die Forscher auf methodologische Annahmen stützen. Insgesamt betrachteten sie nach eigenen Angaben 204 Länder und Gebiete.
Multiresistente Erreger, sogenannte Superbakterien, machen die Behandlung mit Antibiotika unmöglich, sodass selbst leichte Verletzungen und Infektionen zum Tod führen können. Laut der Weltgesundheitsorganisation (WHO) können Resistenzen gegen Antibiotika auf natürliche Weise entstehen; falscher oder übermäßiger Gebrauch von Antibiotika beschleunige diesen Prozess jedoch. Die neue Studie zeigt nach Angaben ihrer Autoren nun, dass Infektionen durch antibiotikaresistente Bakterien für mehr Todesfälle verantwortlich sind als HIV/Aids oder Malaria.
„Diese neuen Daten zeigen das wahre Ausmaß der weltweiten Resistenz gegen Antibiotika und sind ein klares Signal, dass wir jetzt handeln müssen, um die Bedrohung zu bekämpfen“, sagte Experte Murray von der University of Washington. Während frühere Schätzungen davon ausgegangen seien, dass „Superbakterien“ bis 2050 jährlich rund zehn Millionen Menschen töten könnten, zeige die Studie, dass dieser Meilenstein schon viel früher erreicht werden könnte.
„Wir müssen diese Daten nutzen, um unseren Kurs zu korrigieren und Innovationen voranzutreiben, wenn wir im Wettlauf gegen Antibiotika-Resistenzen die Nase vorn haben wollen.“
Die WHO hat die Verbreitung multiresistenter Erreger zur globalen Gesundheitskrise erklärt, eine Arbeitsgruppe soll alternative Behandlungsmethoden untersuchen. Ein Forschungsgebiet etwa befasst sich mit „bakterienfressenden“ Viren, sogenannten Bakteriophagen oder kurz Phagen: Diese Viren erkennen Stämme einer bestimmten Bakterienart, befallen diese und zerstören sie schließlich.
Eine am Dienstag in der Fachzeitschrift „Nature Communications“ veröffentlichte Fallstudie beschreibt, wie Ärzte in Belgien diese Therapie zur Heilung eines Patienten einsetzten, dessen Bein seit fast zwei Jahren infiziert war. Ein Labor in Georgien entdeckte in einer Abwasserprobe die geeigneten Phagen; mit ihrer Hilfe wurde dann die Wunde des Patienten behandelt. In Kombination mit Antibiotika heilte die Phagentherapie laut der Studie die Infektion innerhalb von drei Monaten.
Während Phagen in Russland und Osteuropa schon seit über einem Jahrhundert zur Behandlung von Infektionen eingesetzt werden, werden sie in der EU und den USA weitgehend ignoriert. Dies könnte unter anderem an der Angst vor Viren liegen – obwohl Phagen keine Gefahr für den Menschen darstellen, sagte Mitautorin Anaïs Eskenazi der Nachrichtenagentur AFP: „Bakteriophagen sind nicht in der Lage, menschliche Zellen zu infizieren, sie sind auf Bakterien spezialisiert.“



